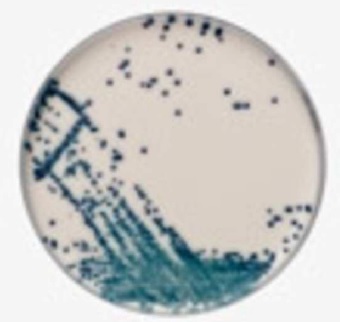

Cargando, por favor espere ...

| Código | Descripción | Disponibilidad | Precio 1x (€) |
Cantidad | Añadir |
|---|---|---|---|---|---|
| 2332PO5170A | Agar Candida Brilliance™, Color blanco ostra, opaco, Monoplaca de 90 mm, paquete de 10 Unid, THERMO SCIENTIFIC« | 15/25 días | 29,48 | 1 |